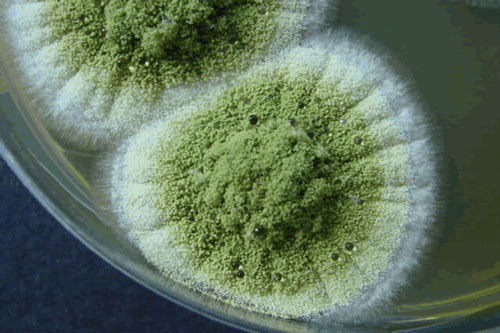
Loài sinh vật siêu nhỏ rất đáng sợ và gần như không thể tiêu diệt

Tìm kiếm: được-chạy
DNVN – Sau khi Đắk Lắk xuất hiện 3 ca dương tính với Covid-19 và thực hiện giãn cách xã hội, Sở GTVT Khánh Hoà đã có văn bản yêu cầu các đơn vị, doanh nghiệp kinh doanh vận tải hành khách khai thác tuyến Nha Trang – Buôn Ma Thuật, chỉ được phép chạy tối đa 1 chuyến/ngày, kết hợp các biện pháp phòng chống dịch bệnh.
Nấm truffle nổi tiếng hiếm hoi và đắt đỏ nhất thế giới. Một nhà ẩm thực nổi tiếng người Pháp ưu ái gọi nó là viên kim cương của nền ẩm thực.
Nhà tiên tri mù Baba Vanga nổi tiểng thế giới có tên gọi đầy đủ là: Vangelia Pandeva Dimitrova, sau khi kết hôn, bà lại đổi tên thành Vangelia Gushterova. Baba Vanga được biết đến là một nhà tiên tri đồng thời là một người chuyên về thảo dược, sống ẩn dật cả đời ở vùng hẻo lánh Kozhuth thuộc Petrich, Bungary.
Bộ ảnh như một cuốn cẩm nang du lịch nhỏ giúp “du khách” dễ dàng hình dung và du lịch vòng quanh thế giới: từ Bắc Kinh đến Berlin, Istanbul đến Paris... chỉ trong nháy mắt.
Bản tin lúc 6h ngày 26/7 của Ban Chỉ đạo Quốc gia Phòng chống dịch COVID-19 cho biết đã có thêm 1 ca bệnh COVID-19 tại Đà Nẵng. Việt Nam hiện có 418 ca bệnh.
11 câu chuyện về những chú chó khuyết tật dưới đây có thể sẽ giúp bạn nạp thêm năng lượng tích cực, để mạnh mẽ hơn trong cuộc sống.
Công nương Kate luôn tìm ra cách nuôi dạy con cái phù hợp nhất với từng tính cách, lứa tuổi.
Samsung Galaxy S20+ BTS, Vsmart Star 4 hay Xiaomi Redmi 9A là những smartphone mới vừa được lên kệ tại thị trường Việt Nam.
Giới nhà giàu luôn có những thú vui vô cùng xa xỉ mà bản thân chúng ta chưa từng nghĩ đến. Đặc biệt, với những món đồ dưới đây, chắc chắn khi có tiền bạn cũng chẳng nghĩ là mình sẽ mua nó.
Hoa hậu Oanh Yến cùng chồng đại gia đưa 6 nhóc tỳ về quê cô - thành phố biển Vũng Tàu - để tận hưởng kỳ nghỉ hè đầy niềm vui.
Một nhóm các nhà thiên văn học sử dụng kính viễn vọng Hubble của NASA thông báo họ đã phát hiện ra một Mặt Trăng mới quay quanh quỹ đạo hành tinh lùn Diêm Vương.
Không chỉ tạo cảm giác ghê sợ, nấm mốc còn ẩn chứa nhiều nguy cơ lây nhiễm bệnh và chúng thật sự rất khó tiêu diệt.
Với sức mạnh của mình, đàn hà mã đã ra đòn chí mạng khiến cá sấu tử vong.
Qualcomm công bố nền tảng di động Snapdragon 865 Plus 5G gia tăng sức mạnh cho điện thoại thông minh
DNVN - Qualcomm Technologies, Inc. vừa chính thức ra mắt Nền tảng di động Qualcomm® Snapdragon ™ 865 Plus 5G. Đây là bước tiếp nối cho thành công của nền tảng di động Qualcomm Snapdragon 865, sản phẩm đã và đang được phát triển trên hơn 140 thiết bị.
Đặc sản An Giang thì có nhiều, món nào cũng ngon cũng thơm. Nhưng có một vài món ăn độc đáo và có phần kỳ dị mà bạn nhất định phải nếm thử khi đặt chân tới vùng đất này.
End of content
Không có tin nào tiếp theo